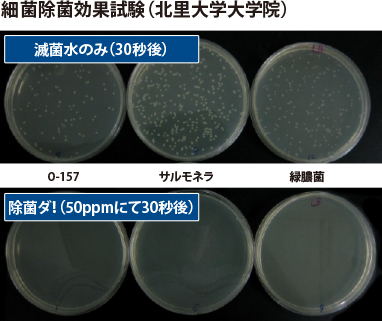

特殊フィルター製法で不純物を取り除き、
純度の高い次亜塩素酸pH調整水溶液に!
純度の高い次亜塩素酸pH調整水溶液に!
「電解法」でなく特許取得された「緩衝法」では
水道水に含まれるカルシウムやマグネシウムもpH緩衝体にて除去し、
高いpHを下げ、低いpHを上げるダブル作用で
安全に除菌効果を高めて、pH4以下には下がりません。
水道水に含まれるカルシウムやマグネシウムもpH緩衝体にて除去し、
高いpHを下げ、低いpHを上げるダブル作用で
安全に除菌効果を高めて、pH4以下には下がりません。

消毒の主役、
次亜塩素酸(HCIO)をpHコントールし
次亜塩素酸pH調整水溶液として
殺菌力を最大限に活かします。
肌とほぼ同じ弱酸性の
pH4〜6.5で肌にも優しい!
pH4〜6.5で肌にも優しい!
人の肌の表面はpH4.5〜6といわれています。
除菌ダ!のpH値は4〜6.5でほぼ同じ値です。
皮膚パッチ試験でも合格していますので
肌についても高い安全性を保っています。
除菌ダ!のpH値は4〜6.5でほぼ同じ値です。
皮膚パッチ試験でも合格していますので
肌についても高い安全性を保っています。

次亜塩素酸pH調整水溶液の力を発揮し
強力除菌・強力消臭!
強力除菌・強力消臭!
塩素を使わない最先端特許製法(1液製法)の次世代活性 次亜塩素酸pH調整水溶液なので、化学反応がなく安心してご使用いただけます。また、特許製法「緩衝法」によって、次亜塩素酸本来の殺菌力を最大限に発揮します。

ノロウィルス、ロタウィルス、ポリオエンテロウイルス、
アデノウイルス等のエンベローブ(脂質性の膜)を
持っていないウイルスにも効果があります。

アルコールとの除菌効果の比較




